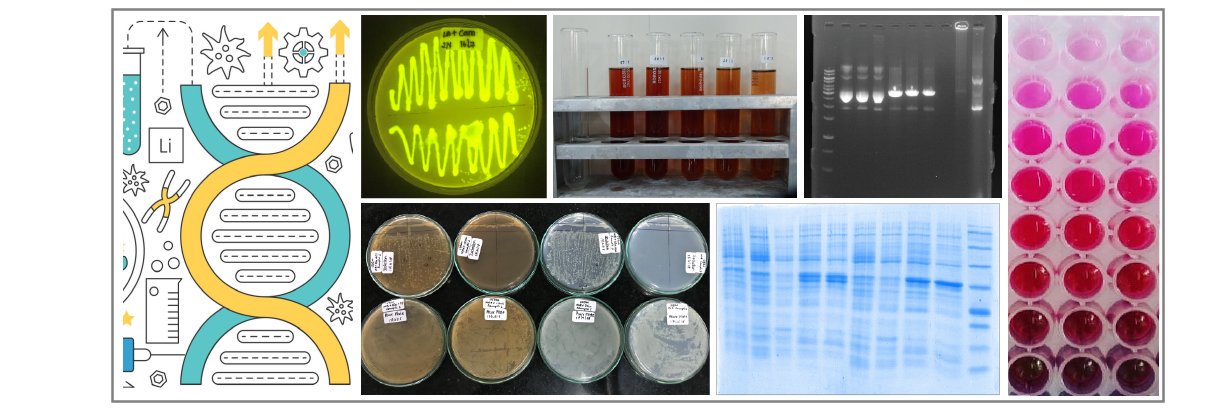
Mayuri Rege banner

Mayuri Rege
3.5K posts

Mayuri Rege
@MayuriRege
Assistant Professor (Reader F) @HBCSE_TIFR Formerly at Ruia College, @Penn, @UmassMedical and @TIFRScience. Views my own.






🇮🇳 Big news from the European Girls' Mathematical Olympiad 2026, Bordeaux, France! India achieves its BEST EVER performance — finishing 6th out of 67 countries 🎉 And… 🥇 India’s FIRST EVER GOLD at EGMO! (egmo.org/countries/coun…) 1/8

















#EMBOWorkshop Registrations for the @EMBO Workshop: Threads of life: SMC complexes in chromosome structure and dynamics are now Open! 🗓️ 13-18 December 2026 📍@ncbs_bangalore, India 🌐Registration & more details: meetings.embo.org/event/26-smc-c… #EMBOThreadsOfLife (1/3) More info 🧵👇🏽






✨Missed the earlier deadline? Here’s another chance! Apply to the TIFR Advanced Programme for women in Physics at HBCSE, TIFR,Mumbai,and explore research methods, Innovative experiments, and mentorship by eminent Scientists. ✨ 📢Deadline Extended - Apply by 19 March 2026.





Science begins with "Why?"—and actually doing an experiment in the textbook. Aamchi Prayogshaala at HBCSE brought two exciting exhibits to our visitors: bacterial motility using dark field microscopy and the amazing Li-Fi (Light Fidelity) technology!



















